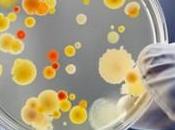
microscopio ottiche adattive

Media Inaf
I MIEI BLOG
-
Media INAF
http://www.media.inaf.it/
Le ultime notizie dallo spazio
ULTIMI ARTICOLI (3071)
-
Kepler trova un ‘cugino’ della Terra

Scoperto il primo pianeta roccioso di dimensioni del tutto simili a quelle della Terra sul quale potrebbe scorrere acqua allo stato liquido: una condizione... Leggere il seguito
Pubblicato il 17 aprile 2014 ASTRONOMIA, RICERCA, SCIENZE -
Come ti scovo l’energia oscura coi neutroni

Uno spettrometro di gravità dell’University of Technology di Vienna. Crediti: TU Vienna È un’aurea di mistero ad avvolgere questa componente di Universo, a... Leggere il seguito
Pubblicato il 17 aprile 2014 ASTRONOMIA, RICERCA, SCIENZE -
Meteo su Marte? Chiedi al geologo

Un frammento di meteorite marziano. Un gruppo di geologi dell’Università del Maryland ha analizzato 40 meteoriti caduti sulla Terra da Marte. Leggere il seguito
Pubblicato il 17 aprile 2014 ASTRONOMIA, RICERCA, SCIENZE -
Eclissi a regola d’arte

Raffaello Sanzio: Isacco e Rebecca spiati da Abimelech. Palazzo Apostolico, Città del Vaticano. Affresco, 1518-1519. Grazie alle moderne tecniche fotografiche... Leggere il seguito
Pubblicato il 17 aprile 2014 ASTRONOMIA, RICERCA, SCIENZE -
La storia dell’universo in un’immagine

L’mmagine presa dal telescopio spaziale Hubble mette in evidenza molte galassie a distanze molto differenti da noi. Crediti: NASA/ESA Guardare questa immagine... Leggere il seguito
Pubblicato il 17 aprile 2014 ASTRONOMIA, RICERCA, SCIENZE -
Tracce di pneumatici su Marte

Credit: NASA/JPL/University of Arizona Tutto pronto per la terza trivellazione su Marte. Il rover della NASA Curiosity, atterrato sul Pianeta rosso il 6 agosto... Leggere il seguito
Pubblicato il 17 aprile 2014 ASTRONOMIA, RICERCA, SCIENZE -
La vita dal mare e non dal brodo primordiale

Un camino idrotermale: questi ambienti hanno forse ospitato le prime forme di vita. Le prime cellule viventi si sarebbero formate nelle fredde profondità... Leggere il seguito
Pubblicato il 16 aprile 2014 ASTRONOMIA, RICERCA, SCIENZE -
Space selfie, se lo scatta Philae

I pannelli fotovoltaici di Rosetta nell’obiettivo dello strumento CIVA montato sul lander Philae. Credit: ESA/Rosetta/Philae/CIVA Dopo Barack Obama, Miley... Leggere il seguito
Pubblicato il 16 aprile 2014 ASTRONOMIA, CURIOSITÀ, RICERCA, SCIENZE -
Il distretto sardo si allarga

Il Distretto aerospaziale della Sardegna (Dass) Scarl si allarga e al suo interno entrano importanti aziende nazionali: Alenia Aermacchi Spa, Nemea Sistemi... Leggere il seguito
Pubblicato il 16 aprile 2014 ASTRONOMIA, RICERCA, SCIENZE -
Orbite pazze, pianeti abitabili

Crediti: NASA’s Goddard Space Flight Center Buone notizie per i cacciatori di vita nello spazio: i pianeti abitabili potrebbero essere segnalati dalla loro... Leggere il seguito
Pubblicato il 16 aprile 2014 ASTRONOMIA, RICERCA, SCIENZE -
Le stelle tingono di rosso l’idrogeno di Gum 41

La regione di formazione stellare Gum 41. Immagine presa dal WFI (Wide Field Imager) montato sul telescopio da 2,2 metri dell’Osservatorio dell’ESO. Crediti: Es... Leggere il seguito
Pubblicato il 16 aprile 2014 ASTRONOMIA, RICERCA, SCIENZE -
Quei germogli trasportati dal razzo SpaceX

Il razzo Falcon 9 in posizione verticale, pronto per la partenza. Crediti: SpaceX A quanto pare l’aereodinamico razzo di ultima generazione Falcon 9 non è nato... Leggere il seguito
Pubblicato il 15 aprile 2014 ASTRONOMIA, RICERCA, SCIENZE -
Guarda che luna (o no?)

L’immagine dell’anello esterno di Saturno in cui è visibile il disturbo forse dovuto alla nuova luna del pianeta. La sonda NASA Cassini ha documentato la... Leggere il seguito
Pubblicato il 15 aprile 2014 ASTRONOMIA, RICERCA, SCIENZE -
Quel lampo di luce dal Buco Nero

Questa rappresentazione artistica mostra i dintorni del buco nero supermassiccio al centro della galassia attiva NGC 3783 nella costellazione australe del... Leggere il seguito
Pubblicato il 15 aprile 2014 ASTRONOMIA, RICERCA, SCIENZE -
Il cuore di Saturno fa girare l’Esagono

L’Esagono di Saturno in un’immagine ripresa dallo strumento ISS a bordo della sonda Cassini il 26 febbraio 2013. Crediti: Planetary Sciences Group UPV/EHU –... Leggere il seguito
Pubblicato il 15 aprile 2014 ASTRONOMIA, RICERCA, SCIENZE -
Via libera per Falcon 9

Il razzo Falcon 9 in preparazione per il lancio. Crediti: SpaceX Partire o non partire? Il dubbio amletico che durante il weekend ha tormentato gli scienziati... Leggere il seguito
Pubblicato il 14 aprile 2014 ASTRONOMIA, RICERCA, SCIENZE -
Il Capo dello Stato riceve Parmitano

“È stata una grande emozione”. Così l’astronauta Luca Parmitano ha commentato l’incontro con il presidente della Repubblica Giorgio Napolitano, avvenuto... Leggere il seguito
Pubblicato il 14 aprile 2014 ASTRONOMIA, RICERCA, SCIENZE, SOCIETÀ -
Un microscopio con ottiche adattive
La complessità della biologia può confondere anche il più sofisticato dei microscopi ottici. Campioni di tessuto sono in grado di piegare la luce in modo... Leggere il seguito
Pubblicato il 14 aprile 2014 ASTRONOMIA, RICERCA, SCIENZE -
Plutone, oceano e tettonica a placche

Rappresentazione artistica di come potrebbe apparire la superficie di Plutone. Sulla sinistra la falce della luna Caronte; sulla destra il Sole, 1000 volte più... Leggere il seguito
Pubblicato il 14 aprile 2014 ASTRONOMIA, RICERCA, SCIENZE -
Quel girino blu nella Costellazione del Cigno

La protostella IRAS 20324+4057. Crediti: NASA, ESA, the Hubble Heritage Team (STScI/AURA), e IPHAS Una protostella a forma di girino è stata fotografata da... Leggere il seguito
Pubblicato il 14 aprile 2014 ASTRONOMIA, RICERCA, SCIENZE
